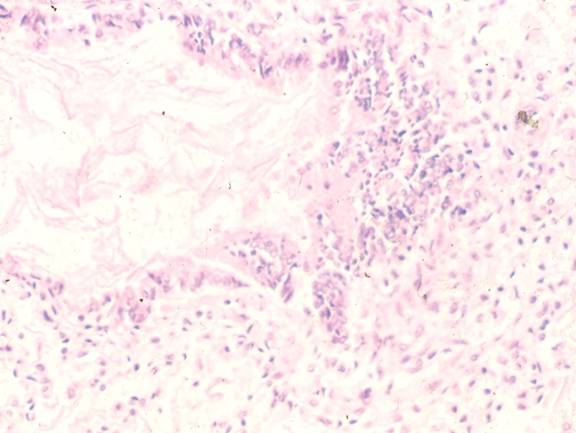
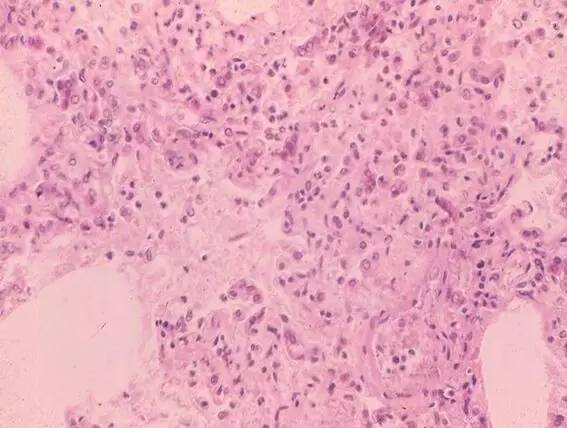

欢迎光临吉康旅!
点击上方蓝字与儿科大咖零距离交流!

作者:何少茹(广东省人民医院儿科主任)
胎粪吸入综合征
发生率
发病机制
胎粪吸入(MAS)
肺动脉高压(PPHN)
临床和研究结果临床特征肺功能影像学图片
治疗
预后
Wiswell et al (1997, U.S.A. )
活产 4,000,000/年
羊水胎粪污染(MASF,10 % ~15%) 400,000 ~ 600,000/年
呼吸窘迫(MAS)5% 20,000 ~ 30,000/年
间歇指令通气IMV(33%) 6,700 ~ 10,000/年
病死率(5%) 1,000 ~ 1,500/年
MAS发生率 0.5% 活产儿
胎粪排出的病因

人类胎粪的特征
水:80%
干重:20%
成分:胎毛,脱落细胞,胎儿皮脂,羊水,肠道分泌物包括胰酶,胆汁酸和胆色素
外观:黑绿或黄绿,粘稠,无臭
促进细菌生长
pH 7.10 ~ 7.20
表面活性物质受抑或失活

MAS功能因素概要
高气道阻力是MAS发生第一个48小时最显著的特征
低顺应性可能过度膨胀或部分性肺不张或终末呼吸单位不张
肺容量(功能残气量FRC,封闭系统氦稀释技术)可能降低或正常
除外气漏,PCO2 通常在正常范围或降低
个体化治疗
MAS通气策略
时间常数↑
使用PEEP
I:E 比 ↓
通气血流比值失调和气漏–高频振荡通气HFOV(<15HZ) 最为合适
表面活性物质治疗
MAS肺动脉高压
发生率:20%~40%
一般特征:-通常在出生后6~24h发生持续低氧血症 -若患儿存活一般3~4天自愈-最常发生功能性血管收缩
MAS肺动脉高压
慢性宫内缺氧引起后腺泡肺毛细血管增生或产生新生血管
缺氧,高碳酸血症或酸中毒导致功能性肺毛细血管收缩
炎症导致功能性肺毛细血管收缩

MAS 幼猪实验
气道吸出:
MAS
↑白三烯 B4 ,C4, D4
↑血栓素 B2
↑6- 酮 PGF1 α
MAS 地塞米松干预
↓血栓素 B2
↓6-酮 PGF1α
幼猪 MAS 实验
( Wu J. M, Yeh T. F. , Wang J. Y. et al Ped. Pulm. 2000, 18: 205-208)
新生猪出生后建立MAS模型,出现肺动脉压升高,双相,早期阶段,从2至6小时;后期阶段,从48小时开始。
气道吸出物中TXB2 , 白三烯 D4 的浓度与平均肺动脉压呈正相关。
使用地塞米松干预可降低气道吸出物中TXB2 和 6-酮PGF1α 的浓度。
地塞米松显著增加心脏每搏输出量,机体平均血压以及改善肺部通气血流比值。
MAS发病机制






MAS影像学表现

临床特征
婴儿胎粪染色
气促,吸气三凹
呻吟
↑A-P 直径
啰音和干啰音
神经系统症状
治疗
预防宫内缺氧
羊膜腔灌注治疗
分娩时吸痰及气管内抽吸
产房治疗
通气治疗
表面活性物质治疗灌洗
吸入一氧化氮治疗
高频振荡通气
体外膜肺
胎粪吸入的时间
宫腔内吸入
MAS : 40%~50% born by C/S
尸检结果
(Brown and Gleicher Obs & Gyn 57:26-29)
MAS 时MAS和血管的研究结果
(Thurren et al: Am J Obs Gyn 176:967-975)
产时吸入
产后吸入

羊膜腔灌注治疗
作用机制
-稀释胎粪
-减压缓冲脐带
操作步骤
-无菌导管进入宫腔
-在重力作 用下以20ml/min 速度注入800ml 无菌生理盐水
-继续注入时速度为2ml/min,最大剂量 为 1500ml
羊水灌注治疗的预后

MAS气管插管抽吸

产房中治疗胎粪污染A.F.

Recommendation
美国儿科学会(AAP 2000)
美国心脏病学会, 新生儿复苏程序(AHA 2000)
1) 无论胎粪性状粘稠或稀薄,皆采取气管内抽吸(2005 AAP 不推荐)
2)若婴儿精神萎靡,呼吸抑制,肌张力下降或心率< 100 beats/min需进行产后气管内抽吸(Wiswell etal, Ped. 2000, 105:1-7)
3)若胎粪粘稠污染羊水,进行羊水灌注治疗
MAS并发PPHN (治疗)
适当的通气支持
高频振荡通气
高频振荡通气+一氧化氮
类固醇 (?)
体外膜肺




PPHN治疗的新方法
钙通道阻滞剂
硝苯地平地尔硫卓维拉帕米
V型磷酸二酯酶(PDES)抑制剂
西地那非
前列环素( PGI2)
依前列醇
曲罗地尔
伊洛前列素
内皮素受体拮抗剂(ETRA)
波生坦
西他生坦和安立生坦
心血管,肺,肾,中枢神经系统窒息的后果
心血管系统窒息的后果
低氧血症相关的肺动脉高压
低氧血症相关的心肌功能障碍
肺窒息的后果
表面活性物质减少
肺水肿
胎粪吸入综合征
肾脏窒息的后果
肾小管和髓质坏死
膀胱麻痹
中枢神经系统窒息的后果
缺血缺氧性脑病
脑室内出血
MAS的预后
立即病死率
气道阻塞
不适当的通气支持
医源性问题
新生儿期病死率
不适当的通气支持
PPHN
长期并发症
宫内缺氧
缺血缺氧性脑病
爱贝儿医征稿邮箱:kefu@cyyz-health.com
详情可咨询爱贝小秘书(微信):kefuxiaobei123
免责声明: 本站关于疾病和药品的介绍仅供参考,实际治疗和用药方案请咨询专业医生和药师。
微信扫码◀
免费咨询电话